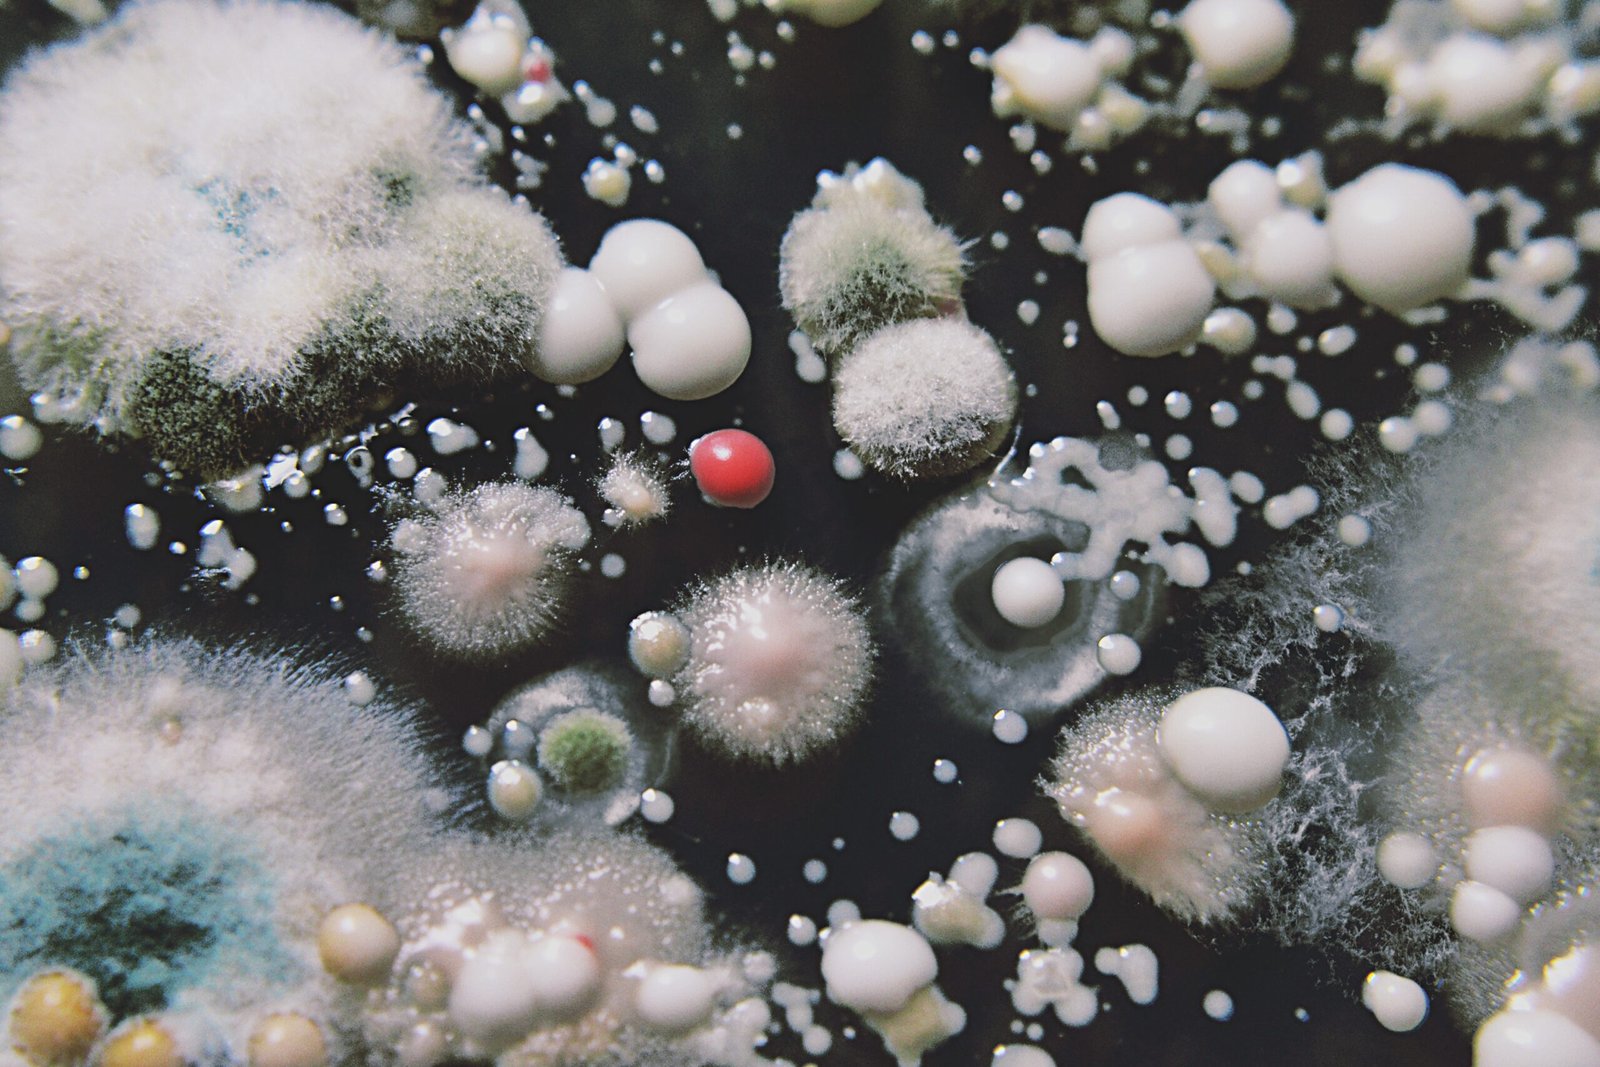
The Concept of Parallel Universes (image credits: wikimedia)

The Fermi Paradox poses one of the most intriguing questions in the field of astrophysics: If the universe is so vast, why haven’t we found evidence of extraterrestrial life? This paradox, named after the physicist Enrico Fermi, challenges our understanding of the cosmos. It raises the possibility that there are factors beyond our current comprehension that might explain the apparent absence of alien civilizations. One such factor could be the existence of parallel universes, a concept that stretches the boundaries of our imagination and scientific understanding.
The Mystery of the Fermi Paradox

The Fermi Paradox hinges on the contradiction between the high probability of extraterrestrial life and the lack of contact with such life forms. Our galaxy, the Milky Way, alone contains billions of stars, many of which likely host planets in the habitable zone. Yet, despite years of searching, we have not detected any signals or signs of alien civilizations. Some argue that this silence is due to the vast distances involved, while others suggest more complex explanations. Could it be that we are simply looking in the wrong place or perhaps even the wrong universe?
The Concept of Parallel Universes
Parallel universes, also known as the multiverse theory, propose that our universe is just one of many. These alternate realities may have different physical laws, constants, and even histories. The idea of parallel universes has been popularized by science fiction, but it also has a basis in scientific theories such as quantum mechanics and string theory. If parallel universes exist, they could provide a solution to the Fermi Paradox by suggesting that alien life exists but in realities we cannot perceive or interact with.
Quantum Mechanics and the Multiverse
Quantum mechanics, the branch of physics that deals with the behavior of particles on an atomic and subatomic level, supports the possibility of parallel universes. According to the Many-Worlds Interpretation of quantum mechanics, every decision or event creates a branching of worlds, each representing a different outcome. This implies a vast number of parallel universes where different versions of reality play out. In some of these universes, intelligent life might have evolved and flourished, but we remain unaware of them due to the separateness of these realities.
String Theory’s Contribution

String theory, another groundbreaking scientific framework, also hints at the existence of multiple universes. It suggests that the fundamental particles of our universe are not point-like but rather one-dimensional strings. These strings vibrate at different frequencies, giving rise to the various particles and forces we observe. String theory posits that our universe is part of a much larger multiverse, with each universe having its own unique set of physical laws. This could mean that alien life, bound by different laws, exists in other universes where conditions are more favorable for its development.
Implications for Extraterrestrial Life

If parallel universes are real, they could vastly expand the realm of possibilities for extraterrestrial life. Life forms in these universes might be unrecognizable to us, shaped by different environments and evolutionary pressures. They might not use technology in ways that we can detect or understand. This perspective shifts the focus from searching for alien life in our own universe to considering the broader context of the multiverse, where life might be abundant but entirely alien to our senses and understanding.
Technological Limitations and Discoveries

Our current technology limits our ability to explore the concept of parallel universes directly. However, advancements in physics and astronomy could provide indirect evidence of their existence. For instance, anomalies in cosmic background radiation or gravitational waves might hint at interactions with other universes. As our tools and techniques improve, we may uncover clues that point to the reality of the multiverse, offering new insights into the Fermi Paradox and the nature of life beyond Earth.
Philosophical Reflections on the Multiverse

The idea of parallel universes also raises profound philosophical questions. If there are infinite versions of ourselves living out different lives in other universes, what does that mean for our sense of identity and purpose? The multiverse challenges our understanding of reality and prompts us to reconsider our place in the cosmos. It invites us to explore the boundaries of human knowledge and imagination, pushing the limits of what we consider possible.
The Role of Human Imagination
Human imagination has always been a driving force behind scientific discovery. The concept of parallel universes, while still theoretical, inspires scientists and thinkers to explore new ideas and possibilities. It encourages us to look beyond the known and question the assumptions that limit our understanding of the universe. By embracing the unknown and the uncertain, we open ourselves to new avenues of inquiry and discovery.
The Future of the Fermi Paradox

As we continue to explore the universe and develop new technologies, the Fermi Paradox remains a central question in our quest for understanding. Parallel universes offer a tantalizing possibility that could redefine our search for extraterrestrial life. Whether or not we find evidence of these alternate realities, the pursuit of knowledge drives us to explore the mysteries of the cosmos and our place within it. Science, like the universe itself, is ever-expanding, and the answers we seek may lie beyond the horizons of our current understanding.
Final Thoughts on Parallel Universes and the Fermi Paradox
The exploration of parallel universes as a potential answer to the Fermi Paradox is both fascinating and challenging. It encourages us to think beyond the constraints of our universe and consider the vastness of possibilities that lie beyond. While the existence of parallel universes remains unproven, the concept pushes the boundaries of science and philosophy, inviting us to question the very nature of reality. As we ponder the Fermi Paradox and the potential of the multiverse, we are reminded of the endless wonders that the universe holds and the enduring human spirit of curiosity that drives us to seek answers.



